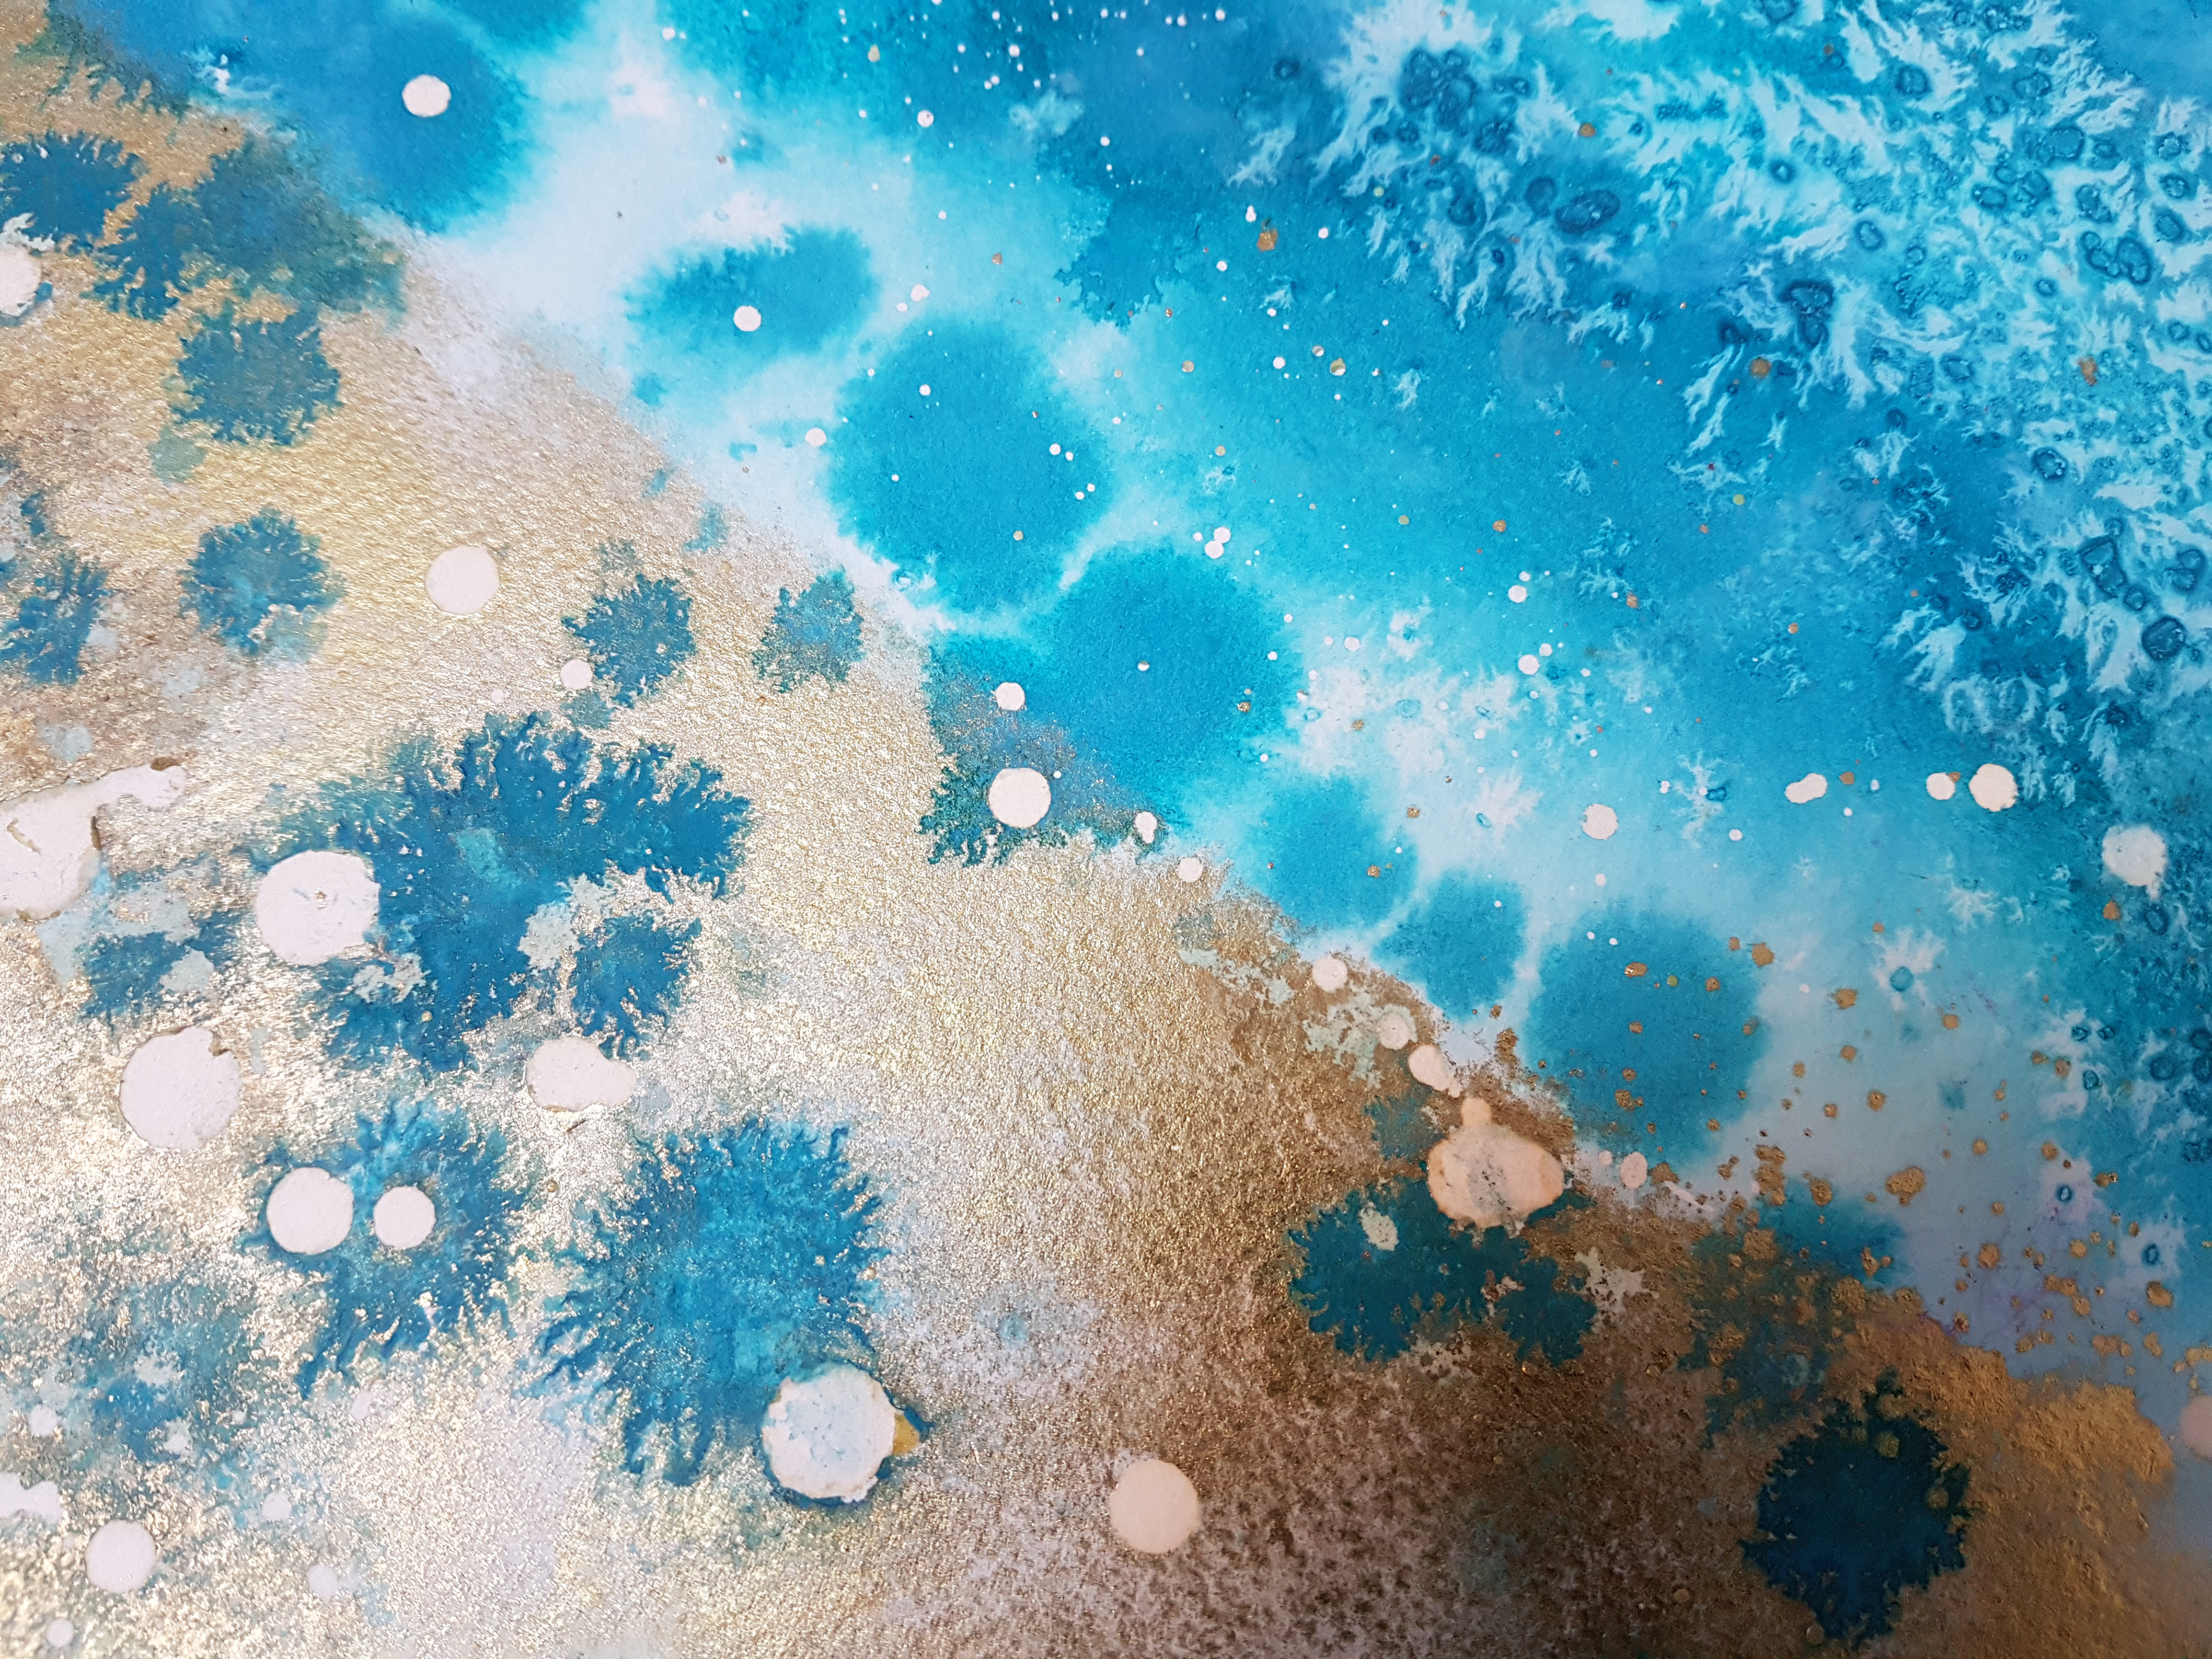

A large 100x80cm turquoise and gold abstract commission inspired by the mesmeric light in a coral atoll (aeriel view).
Washed heavily with gold ink and textured with salt.
Framed in anti-UV glass and encased in a lime-waxed frame.
Ink Art Abstract Commission in Turquoise and Gold